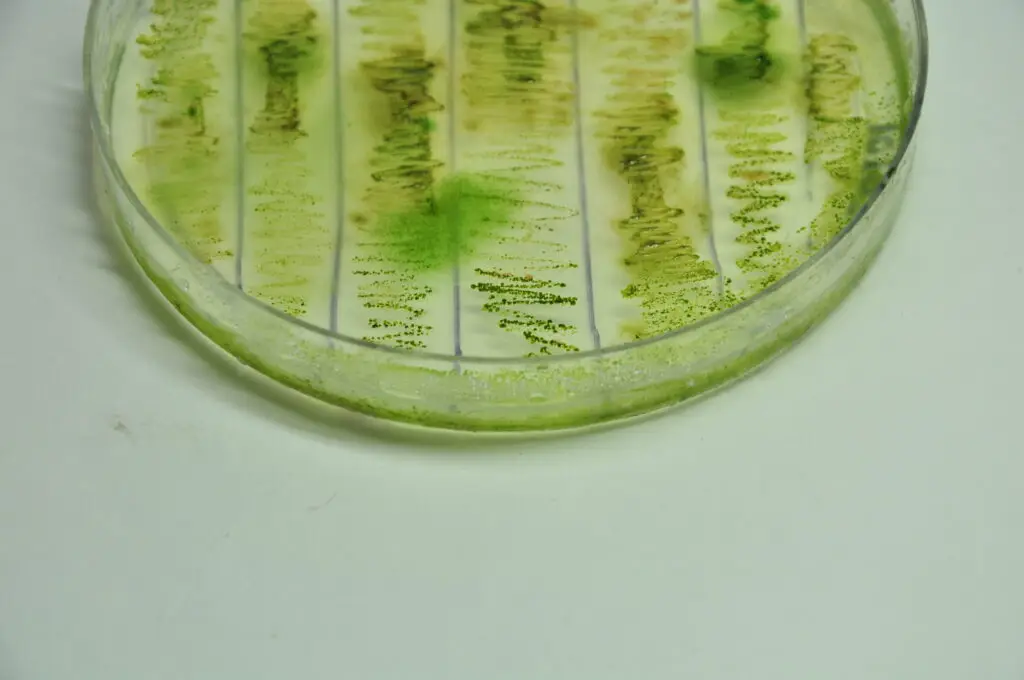
dsc0166

About Us
We warmly welcome you to BiologikaHub, your trusted online hub for Biology, Microbiology, Botany, and Computer Science education. Explore research insights, study materials, and trending scientific updates designed for graduate and university students. Stay informed with latest science facts, technology tutorials, and academic resources curated for passionate learners and science enthusiasts.
A passion for easy and interactive learning
-
Graduate Study Resources – Access Biology notes, Microbiology summaries, and Botany mind maps crafted for exam success.
-
Research Insights – Stay updated on current trends in life sciences, biotechnology, and computational biology.
-
Interactive Learning – Engage with concise PDF notes, mind dumps, and question banks tailored for university-level study.

An array of resources


- Consulting
- Project Management
- Continuous Support
Download Study material
- A world of thought-provoking articles
- Concise resource materials.
- Easy Downloadable .pdf, .doc.

Quiz
- Exam friendly question paper.
-
Evaluation matrix.
-
Answers and mind dump.
Stay Connected
-
Newsletters & Science Updates – Get fresh insights on new technologies, scientific discoveries, and research breakthroughs.
-
Tech & Tutorials – Learn from step-by-step guides, computer tutorials, and trending science news analysis.
-
Community Learning – Connect with a growing network of students, educators, and researchers sharing academic ideas.

“Be a biologist: refresh, rethink, recycle your thoughts.”
